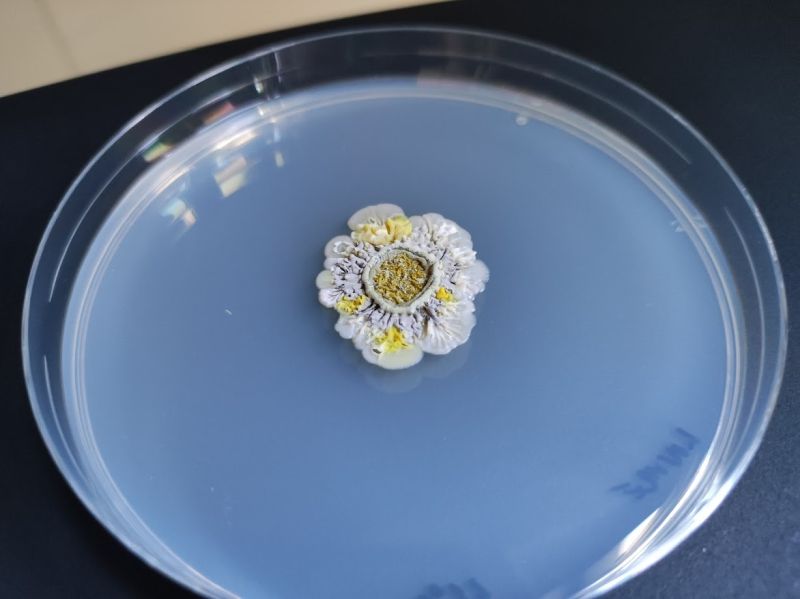
Bakterie zkoumané na Antarktidě

V e-mailu jste mi popisovala, že jste aktuálně v předodjezdové horečce. Mohla byste stručně popsat, co všechno musíte před odjezdem na expedici zařídit?
Odjezd na Antarktidu je velmi náročný a má dvě fáze. Ta první je na konci léta, někdy na přelomu srpna a září, kdy odesíláme takzvané cargo. To znamená, že už v tom bodě musíme mít perfektně naplánováno, co chceme dělat a co k tomu budeme potřebovat. Co nepošlete, to na místě nebudete mít k dispozici. To je vždy horečka číslo jedna – objednat všechny věci tak, aby stihly dorazit. Teď probíhá ta druhá fáze, kdy odesíláme lidské jednotky. To je komplikované v tom, že je to kombinace nejen vašeho výzkumu, ale i výzkumu jiných kolegů, kteří s vámi na expedici jedou. To znamená: kdokoli chce nějaký specifický odběr vzorků a oslovil mě, já s tím člověkem musím projít jeho odběrový standardní operační postup, aby odebrané vzorky splnily podmínky pro zařazení do jejich výzkumu. Zda na to máme vše, co potřebujeme, jestli to kolega poslal, nebo zda musíme ještě něco vzít v rámci přesunu samotné expedice. A tohle je logistika, která před odjezdem zabere strašně moc času. Kromě toho je předodjezdová horečka spojená i s vybavením, které si na Antarktidu odvezete. V mém případě je to letos jednodušší, protože mám veškeré vybavení už z předchozí expedice. Takže teď už nemusím řešit bundy, kalhoty, boty a podobně, což je super, protože když jsem tam jela poprvé, tak mi zabralo asi čtyři měsíce, než jsem vůbec vyřešila, v čem budu na Antarktidě oblečená. Letos se mi k tomu všemu ještě přidala slušná porce papírování navíc. Oproti minulé expedici jsem už vedoucí vlastní výzkumné skupiny, což znamená, že musím v tomhle bodě vyřešit celou byrokracii, kterou nepůjde řešit z Antarktidy. Cokoli, co je třeba zadat do systému, podepisovat papíry, vystavit dohody, stipendia apod. To je úroveň, kterou jsem před pěti lety neměla a je v mnoha ohledech náročnější než věci, které musíte řešit jako výzkumník, který nemá na starosti skupinu dalších lidí.
Jste neustále na sluníčku, zároveň je vám pořád zima, nemáte optimální spánkové podmínky. Tělo prostě dostane dvojnásobný záběr.
To zní jako velmi náročný proces, ale předpokládám, že ne úplně na všechno se dá připravit. Stejně tam přijdou situace, kdy budete muset jednat ad hoc…
Ano, tohle se nikdy nepodaří připravit na sto procent, a jelikož jsem taky jenom obyčejný člověk, tak jsem určitě na něco zapomněla. Já samozřejmě vždycky doufám, že ne, ale přímo na místě pak můžu zjistit, že třeba nemám zapalovač, abych si mohla vysterilizovat materiál, nebo něco podobného. Takové detaily se prostě objeví. Na druhou stranu, jedeme tam ve dvaceti lidech. Vždy je šance, že vás zachrání kolega, nebo se prostě bude muset improvizovat. Uvidíme, po Antarktidě vám povím, na co jsem zapomněla.
Jsem na to zvědavá. Jak se vlastně žije na polární stanici, kromě pohybu v terénu?
Ráno vstanete a dáte si snídani. Tedy – když jste bláznivá jako já, jdete si ještě zaběhat na pláž nebo dát ranní trénink, protože se rádi hýbete. Musím říct, že naposledy jsem ale podcenila, jak náročný terén v Antarktidě je. Jela jsem tam s představou, že budu mít stejné množství pohybu jako doma, abych nevypadla z kondice, a pak jsem se vrátila hrozně přetížená. Jste neustále na sluníčku, zároveň je vám pořád zima, nemáte optimální spánkové podmínky. Tělo prostě dostane dvojnásobný záběr. Teď už vím, že se letos budu více hlídat. Po pohybové aktivitě přichází snídaně. Kolegové vstanou a jdou na snídani. Tu vždycky chystají ti, kteří mají daný den službu. Ti jsou zodpovědní za jídlo, praní a běžný provoz stanice. Střídáme se ve dvojicích. Ráno je také briefing – rozdělí se, kdo kam jde, do které části ostrova. Do některých částí může člověk sám, pokud jsou blízko stanice, ale jinak se chodí ve dvojicích, trojicích a na ledovce kvůli bezpečnosti až ve čtveřicích. Taky se plánuje, kdo se kdy vrátí. S logistikou se řeší i předpověď počasí na daný den nebo na dva nejbližší – to nám zajišťují klimatologové v týmu. Delší předpovědi nemají smysl, protože počasí na Antarktidě se extrémně mění. Klimatologové jsou velmi důležití, mimo vlastní vědeckou práci se starají o bezpečnost lidí na expedici z hlediska terénní práce. Abychom nešli do terénu a za tři hodiny nepřišlo šílené počasí…

To narážíte na moji další otázku. Jaké jsou největší bezpečnostní výzvy kromě počasí, které jste zmínila?
Kdybych šla zpětně po vzpomínkách, pro mě byl největší bezpečnostní výzvou určitě pohyb na malých člunech, které používáte, když se chcete dostat do jiné části ostrova nebo na přilehlé ostrůvky. Tam se jezdí na tzv. zodiacích. Já jsem zažila dvě jízdy a obě patří k mým nejhorším vzpomínkám z hlediska toho, jak nebezpečné byly. Druhou velkou výzvou je pohyb po ledovcích. To je terén, kde nevíte, jestli se pod vámi něco nemůže propadnout, jestli tam nejsou trhliny. Proto tam musí jít až čtyři lidé, kteří se jistí navzájem. Takže podle mě tyto dvě věci jsou bezpečnostně nejrizikovější.
Možná úplně laická otázka, ale u toho pohybu na malých člunech hrozí, že spadnete do vody?
My jsme třeba měli situaci, kdy se na člunu porouchal motor a byli jsme velmi daleko od stanice. Varianty byly, že se nám to buď podaří na koleni opravit, nebo půjdeme ve voděodolných overalech pěšky přes ostrov. Druhá věc je pohyb ledových ker. Zažila jsem situaci, kdy jsme vyjeli v nádherném počasí, čistý průplav, a když jsme se vraceli, tak se průplav během pěti minut zasypal ledem. Ty kry jsou násobně větší než malý motorový člun. Nejde ani tak o převržení, ale o to, že vás mohou odnést na otevřené moře. A odtamtud se nemáte šanci vrátit. To je za mě opravdu rizikové a lidé si to uvědomují, takže pokud to není nezbytně nutné kvůli vědeckému cíli, čluny se jako primární volba nevolí. Další nebezpečí na člunech jsou kosatky. Já jsem to nikdy nezažila, nikdy nám na člun neskočila, ale je to něco, s čím se musí počítat.

Když jste byla v Antarktidě naposledy, vaším primárním fokusem byl výzkum mikroorganismů (mikrobiálních mikrokomunit), které by mohly být účinnou zbraní proti antibiotické rezistenci. S jakým cílem jedete na Antarktidu teď?
Když jsem tam jela poprvé, cílem bylo vytvořit jakousi subkolekci půdních bakterií. Ty se dřív moc nesbíraly a z dostupných dat víme, že půdní mikroorganismy jsou extrémně nadané v produkci bioaktivních látek, což je tedy moje hlavní téma. Letos budeme sledovat diverzitu bioaktivních peptidů, které ty bakterie produkují. U Antarktidy platí jedna zásadní věc: pokud jde o bioaktivitu, nemáme srovnávací data z jiných ekosystémů. Budeme tedy sekvenovat metanogeny, pracovat s transekty, sledovat komunitu podél gradientu vody a dostupnosti vlhkosti. A také zkoumat různé stáří půdy: jak se mění mikrobiota podle toho, kdy z místa ustoupil ledovec. Součástí toho bude i metodický výstup – ověřujeme, jestli dokážeme tyto mikrobiální komunity vůbec správně sekvenovat a sbírat. Do toho jsme se rozhodli investovat, protože máme pocit, že přístup, který dnes standardně všichni používáme, není úplně ideální. A ještě budeme zkoušet jednu věc: detekci peptidů přímo v prostředí. Nikdo zatím přesně neví, jaké bioaktivní látky ty bakterie reálně produkují ve svých přirozených podmínkách. V laboratoři je totiž většinou neprodukují téměř vůbec. Existuje celosvětová hypotéza, že produkují jen tehdy, když reagují na prostředí. Tak jsme si řekli, že zkusíme jednoduchou matrici někde na ledovcích, kde není moc „balastu“, například z půdy, a pokusíme se ty peptidy přímo zachytit a pak je spárovat s genetickou informací. Je to zajímavé, ale komplikované to v tom terénu provést. Teď chceme aspoň začít a uvidíme, zda z toho dostaneme smysluplná data. Dalo by se tedy říci, že jsme ten výzkum rozdělili na vidličku, kdy na jedné straně zkoumáme ty látky jako takové a jejich použití a na druhé straně řešíme základní otázky, tedy proč a jak tyto látky v mikroorganismech vznikají, za jakých okolností a za jakým účelem je produkují, jak vůbec v extrémním prostředí vypadají a fungují.
Tím využitím tedy myslíte farmacii…
A také například kosmetologii. Mikroorganismy, se kterými pracujeme, jsou perfektně UV rezistentní a většinou to jsou pigmenty, což jsou strašně fascinující látky na použití v protektivních UV faktorech do kosmetiky. A zase, nikdo na to v té Antarktidě přímo nesahá, protože je náročné s antarktickými mikroorganismy pracovat, ale myslím si, že ani nevíme, kde ten biotechnologický potenciál končí. Je to výzkum, který mě pohání sám od sebe dopředu, ale jsou momenty, kdy na něco musím říct ne. A to jsou velmi těžké momenty.
Vzhledem k tomu, že Antarktida je hodně chráněná oblast, předpokládám, že máte v terénu omezení, jak se chovat vůči prostředí…
Určitě. A každý rok se to trochu mění. Když se sestaví expedice a ví se, kdo jede, musíme za své projekty připravit seznam typů materiálů, které chceme odebírat, a v jakých množstvích. To musí schválit Ministerstvo životního prostředí. Administrativu za nás dělá Český antarktický výzkumný program. Na ostrově Jamese Rosse nemáme tzv. speciálně chráněné oblasti (např. ASPA), kam by bylo potřeba zvláštní povolení, o které se musí žádat ještě separátně. Ale jsou lokality, kde by to nutné bylo, například v případě Deception Islandu. Tam existují extrémně unikátní komunity, takže se tam nesmí ani šlapat, člověk má zasáhnout co nejméně, odebrat minimum a hned pryč. A co se týče obecných pravidel: nešlape se po citlivých vegetačních komunitách – mech, lišejníky, mikrobiální povlaky. A u živočichů platí, že se jich nesmíme dotýkat, protože náš lidský mikrobiom pro ně může být potenciálně nebezpečný. V minulých letech se mohly odebírat třeba výkaly nebo stěry z kloak u tučňáků nebo nozder tuleňů, ale od doby, co se v Antarktidě objevila ptačí chřipka, je absolutní zákaz přibližovat se ke zvířatům. Ostatně by nebylo nic horšího, než kdyby celá expedice chytila ptačí chřipku.
Polární výzkum bývá převážně mužskou doménou, například všechny vedoucí pozice v Českém antarktickém výzkumném programu v současnosti zastávají muži. Víte, v jaké fázi kariérního postupu ženy z výzkumu nejčastěji „mizí“?
Je to kombinace více faktorů. Ve STEM (koncept propojení přírodních věd, technologií, inženýrství a matematiky, pozn. autorky) oborech bývá na úrovni Ph.D. zastoupení žen a mužů celkem vyrovnané, někdy dokonce ženy mírně převažují. Jakmile se ale podíváme na vyšší kariérní stupně, jejich počet výrazně klesá – často na 20–30 %, rozhodně ne na poměr jedna ku jedné. Podle mě je první velký zlom ve chvíli, kdy člověk dokončuje doktorát a přechází do postdoktorského období. To se totiž časově překrývá s obdobím, kdy mnoho lidí zakládá rodinu. A tam nastává první „vypadnutí“. V Česku je problém i v tom, že rodičovská bývá dlouhá – a není to jen tím, že by si ji ženy samy chtěly prodlužovat. Pokud nemáte podporu širší rodiny, často zkrátka nemáte dítě komu svěřit. A po tak dlouhé pauze se pak ženám často jen těžko naskakuje zpátky. Další problém spočívá v nedostatečné podpoře ženských talentů. Můžu mít skvělou doktorandku nebo postdoktorandku, která odejde na mateřskou. Ideální by bylo, kdyby se mohla postupně vracet alespoň na menší úvazek. Podle mě nám ale stále chybí know-how, jak tyto ženy v prostředí výzkumu udržet. Přitom by to šlo řešit různými flexibilními mechanismy – například prací na pár hodin denně, možností zaměřit se na vyhodnocování dat místo experimentů nebo vedením studentů. Prostě tak, aby úplně nevypadly a mohly se později snadněji vrátit. Jenže na tohle nebývá trpělivost. Když jsem dokončila Ph.D. já, bylo mi přímo řečeno, že mám přestat přemýšlet o vědě a začít rodit. Úplně jsem oněměla, protože pro mě nikdy nebylo představitelné, že bych se vědy vzdala – ale najednou bylo rozhodnuto za mě.
Podle mě nám chybí know-how, jak ženy v prostředí výzkumu udržet.
Vy sama se dlouhodobě snažíte zvyšovat povědomí o situaci žen ve vědě. Byly to právě tyhle osobní momenty genderové nerovnosti, které vás k tomu přivedly?
Byla bych hrozně ráda, kdyby si už nikdo nemusel projít tím, čím jsem si musela projít já. A je velká pravděpodobnost, že když o tom budu veřejně mluvit, tak se to nějakým způsobem bude řešit. Jako Ph.D. studentka jsem netušila, na koho se obrátit, a jen jsem zatnula zuby a proboxovala jsem to, ale přitom tohle není správný způsob fungování. A když se ptám současných studentek, často jsou na tom stejně, i když už máme ombudsosoby a různé regulace. Stále se stává, že Ph.D. studentka, která například zažívá sexuální obtěžování, vůbec neví, kam jít, bojí se, že nedokončí Ph.D., a do toho se přidává hierarchická „power-play“, která v akademii pořád existuje. Chci, aby se tohle nedělo. Jsme ve 21. století a měli bychom se k sobě chovat s respektem.
Zdá se, že se v takových situacích vyplácí nějaký systém mentoringu…
Určitě. Myslím si, že je skvělé mít mentorku i mentora, protože každý z nich přináší úplně jiný pohled a jiné zkušenosti. V tomhle je neuvěřitelně pokrokové Rakousko – mají mentoringové programy pro postdoky, kde se v rámci setkání dva či tři na jednoho skutečně řeší i takovéto situace. Problémy jsou tam podobné jako u nás, ale způsoby, jak se s nimi pracuje, jsou mnohem efektivnější. U nás tak zbytečně přicházíme o obrovské množství potenciálu, protože právě v těchto chvílích ženy často z akademie odcházejí. Je to pro mě hluboké a náročné téma, které se těžko řeší. Doufám ale, že lidem, které mám kolem sebe, dokážu předat podobný přístup a že ta změna bude postupně vznikat napříč generacemi. Díky vlastní zkušenosti vím, jak zásadní je funkční a respektující pracovní prostředí, a proto se ve svém týmu snažím podporovat rovnocenný přístup. Muži, kteří jím projdou, vnímají své kolegyně jako sobě rovné. Nejsem v tom navíc sama – ve vědě mám, krom kolegyň, také mnoho mužských kolegů, kteří tento problém reflektují a podobný přístup sami předávají dál. I proto věřím, že změna je možná, byť postupná.
Předplaťte si časopis Nový Prostor a každé nové číslo dostanete elektronicky nebo poštou přímo do schránky! I při objednání přes internet můžete podpořit svého oblíbeného prodejce.





